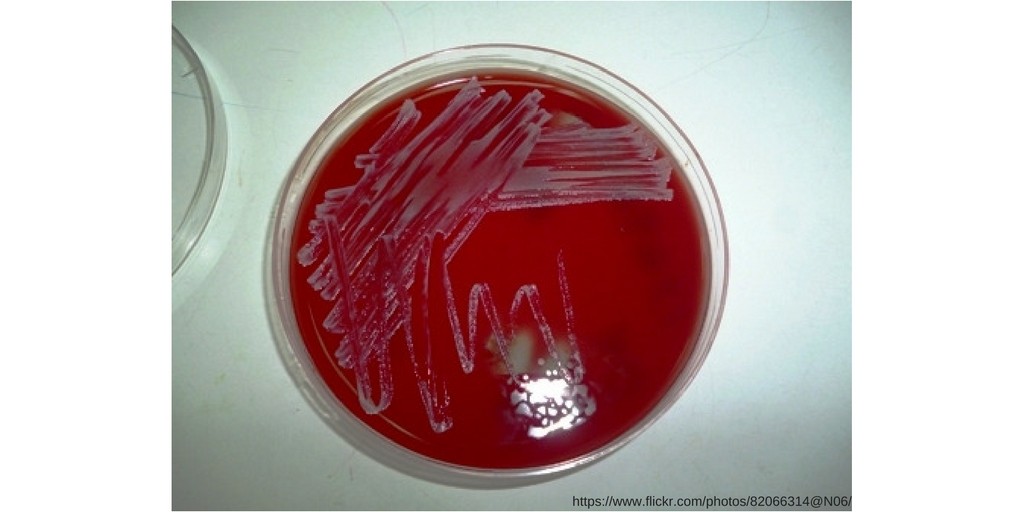

coagulase negative staph in urine
Coagulase-Negative Staphylococci | Clinical Microbiology Reviews» Infectious diseases Negative coagulase Staphylococci OVERVIEW: What each clinician needs to know Pathogen name and classification There are more than 45 recognized species of coagulase-negative stafilococci (CoNS). The coNS are grampositive coccis that are divided into irregular clusters "like the aureus" and differ from S. aureus because of their inability to produce coagulase and coagulate rabbit plasma. CoNS species that have important traits and are more frequently associated with clinical disease are S. epidermidis (infections of biomaterial devices and prosthesis), S. lugdunensis (skin infections and soft tissue, bacteremia, endocarditis), S. saprophyticus (non-complicated urinary tract infections in sexually active women), and S. What's the best treatment? Vancomycin is generally the cornerstone for the treatment of infections due to S. epidermidis and other CoNS, since 80-90% of the strains responsible for nosocomial infections are resistant to semi-synthetic penicillins, stable penicillins, such as oxacillin and naphcillin. The dose of vancomycin is based on real weight and kidney function. The benefit of higher-dose vancomycin (a tos level of 15-20 ug/mL) is not well defined for CNS infections and can lead to increased risk of nephrotoxicity. Many doctors add rifampin (600 mg/day) to regimes that contain vancomycin when treating a biomaterial-based infection (prosthesis joint infection, prosthesis valve endocarditis, etc.). A feature of CNS infections involving medical devices (intravascular catheters, vascular grafts, prosthesis joints, CSF hunts, etc.) is the presence of biofilm and "persister" cells. CNS associated with biofilm is usually much less susceptible to antibiotics than plankton cells, and often effective therapy of biomaterial-based infections requires the removal of the device. CNS responsible for nosocomial infections are almost always resistant to multiple kinds of antimicrobial agents. Approximately 95% of S. epidermidis strains isolated from well-defined health-related infections are resistant to penicillins due to beta-lactamasa production. Most strains are also resistant to methicillin due to the medium-sized mecA production of PBP2A. More complication of the image is the fact that the phenotypic expression of resistance to methicillin is much more heterotypic than observed in S. aureus. In addition, resistance to other types of antibiotics is common, including resistance to fluoroquinolls, macrolide, lymphcosamide and trimeterprim-sulfamethoxazol. To detect heterotypic oxacillin resistance in CoNS, the MIC breakage point is lower for CoNS (except S. lugdunensis) than S. aureus (0.5 ug/mL versus 4 ug/mL, respectively). Commercial tests are available for detection of mecA or PBP2A. Automated identification and susceptibility testing systems available commercially (e.g., MicroScan, Vitek, etc.) meet adequately in defining susceptibility to other antibiotic classes. Fortunately, several new antibiotics have been introduced that have activity against the multi-resistent CNS. These new antibiotics include linzolid, daptomycin, tigecycline quinupristin-dalfopristin, televancin and ceftaroline. How do patients get this infection, and how to prevent the spread to other patients? Epidemiology CNS are common flora of human skin and mucous membranes and rarely cause primary disease. Its pathogenic potential lies in its ability to colonize biomaterials and cause infections of medical devices. CoNS, in large part S. epidermidis, is the main cause of nosocomial infections in the bloodstream and is responsible for approximately 30% of these infections, which are mainly due to intravascular catheters. Similarly, coNS are a major cause of several other infections associated with devices, including vascular grafts, cephalorachemical fluid sinks (CSF), prosthesis joints and artificial heart valves. Since the use of such devices has increased in developed countries, the incidence of infection due to CNS has increased in tandem. Pulse field gel electrophoresis (PFGE) is generally considered as the best test to address short-term molecular epidemiology issues. There is a great diversity in pulse field patterns. Finding indistinguishable PFGE patterns in the context of a outbreak or in complex clinical situations is a reliable indicator of cloning. Long-term population analysis is best addressed through the classification of multiple locus sequences (MLST). Infection Control Problems CNS are ubiquitously present in human skin and lack the intrinsic virulence of S. aureus. Standard measures of infection control (manual hygiene, routine environmental cleaning and disinfection) are adequate. The prevention of infection due to CNS becomes more relevant in the establishment of surgical implants of prosthetic medical devices and the insertion and care of intravascular catheters. Central venous catheters should be inserted using full sterile barrier precautions after skin disinfection with chlorhexidine. The insertion and maintenance of catheter can be successfully introduced using a "bundle" approach. In the O.R., when a prosthesis device is to be placed, great care must be exercised in the preparation of the skin on the operating site with an emphasis on the proper disinfection of the skin and the removal of the hair, if necessary, by using surgical clamps. Many surgeons choose to use vancomycin as a prophylactic antibiotic when a prosthesis device is placed in which the contamination and infection due to the disease is relevant (heart valve, prosthesis joint, vascular graft, etc.). Although it's about developing a vaccine against Epidermidis S is underway, there is currently no commercial vaccine available for CNS. What host factors protect against this infection? The key factor of the immune system that protects against CoNS invasion is intact skin and mucous barriers and functional neutrophils. Patients with the highest risk of infection due to CNS infection are those with intravascular catheters and prosthesis medical devices. In addition, neonates and neutropenic patients are at increased risk of infection. S. saprophyticus causes urinary infection in premenopausal, sexually active women. S. lugdunensis behaves more like S. aureus than other CoNS and can cause invasive infection in normal hosts. Histopathology of infections associated with CoNS biomaterials often reveals evidence of acute and chronic inflammation, as well as foreign body reaction (multiple core giant cells). In animal models of infection associated with biomaterial of CoNS treated with antibiotics, organisms are often cleaned from the immediate interface between the device and the tissue but persist in the peri-implant tissues. In addition, viable organisms often recover from biofilm which is a distinctive seal of biomaterial infections of CoNS. What are the clinical manifestations of infection with this organism? S. epidermidis is more commonly associated with medical device infections. Infections are often painless and can be clinically difficult to define. Differing the contamination of the culture of true infection can be difficult. Intravascular catheter Infections: CoNS, usually S. epidermidis, are the most common cause of intravascular catheter infections. Although patients with infected intravascular catheters may present signs of sepsis (bacteremia, hypotension, etc.), the catheter site itself is usually unaware. Occasionally, there are local signs of inflammation or purulent drainage at the catheter site. In general, central venous catheters (CVCs) infected with short-term and unmanned CoNS should be eliminated. In patients with long-term infected CVC that have no signs of severe sepsis, it is reasonable to try treatment with the in-situ catheter. Aesthetic valve endocarditis (PVE): CoNS causes 15-40% of PVE cases. Patients may present acutely or in a more painless way. Clinical manifestations include fever and evidence of valve dysfunction. The diagnosis is confirmed by documenting persistently positive blood cultures and finding evidence of endocarditis via transesophageal echocardiogram. Surgery is almost always necessary, and antibiotic treatment usually consists of a combination of vancomycin and rifampine, often with gentamicin during the first 2 weeks. Clothes infection: CNS represent 50-60% of pacemaker endocarditis. Patients usually present evidence of inflammation at the generator's pocket site along with positive blood cultures. Transesophageal echocardiography is recommended for all patients with suspicious pacemaker infection, and successful treatment usually requires the complete removal of the device. Graft vascular infection: 20-30% of vascular graft infections are caused by CoNS. Infections usually occur in pain for weeks to months with a false aneurysm, fistula or sinusitis at the graft site. Blood cultures can be negative, as the infection cannot spread to the graft lumen. Surgery is necessary to cure and prolonged antibiotic therapy is often used. Orthopedic Infections: CoNS causes 30-45% of prosthesis infections. Although most of these infections are believed to come from the contamination of the device at the time of implantation, the presentation of the infection may be delayed for months or years. Joint pain is usually the only symptom, and fever or other systemic signs or symptoms are rare. The diagnosis is supported by the search for elevated inflammatory markers (Trocyte sedimentation rate, C reactive protein). The cure is better secured with a two-step exchange procedure and 6-8 weeks of antibiotic therapy. Cerebrospinal Fluid Shunt Infections: CoNS causes about half of CSF shunts infections. Signs and symptoms of CSF shunt infection are usually developed within 2-3 months of shunt implantation and consist of local signs of inflammation, as well as fever, nausea, vomiting, malfunction of shunt, and increased intracranial pressure. The diagnosis is confirmed by the recovery of CSF CNS obtained from shunt. As is true of most infections of prosthesis devices, surgical removal is generally necessary and antibiotic treatment is used with active agents against methicillin-resistant strains. In the case of CSF shunt infections, vancomycin and gentamicin are often given intraventricularally and rifampin is given orally. Peritoneal dialysis Catheter-Associated Peritonitis: CNS represents 25-50% of peritoneal dialysis-associated peritonitis. The manifestations of infection include abdominal pain and tenderness, fever, nausea and vomiting. Unlike other prosthetic devices infections, peritonitis associated with peritoneal catheter can often be successfully treated with antibiotics in the dialysate fluid without the removal of the catheter. However, recalcitrant peritonitis is an indication for the elimination of the catheter. Other common infections of the CoNS prosthetic device: Endophthalmitis after intraocular implantation of lenses Breast implant infectionProsthesis infection Left ventricle assistance device and other heart device infections Mesh surgeryInfections from S. lugdunensis present in an acute form similar to S. aureus infections. Common infections include skin infection and soft tissue (e.g. cellulite, furunculosis) and native valve endocarditis. S. saprophyticus is a common cause of urinary infection in premenopausal women and has typical signs and symptoms, such as urgency, frequency, disssury and pelvic discomfort. Pyuria and hematuria are common. For unknown reasons, urinary tract infection S. saprophyticus has a late and fall seasonal predilection and often follows sexual or menstruation. What common complications are associated with infection with this pathogen? Complications of infection due to CoNS infection are usually due to the direct extent of infection in the tissues of the peri-medical device and/or to the dysfunction of the device. For example, as endocarditis of the CoNS prosthetic valve progresses, valve dysfunction, heart failure and heart conduction anomalies develop. Because CNS does not produce exotoxins or other pro-inflammatory compounds (as S. aureus does), patients rarely develop signs of severe sepsis or septic shock, even with endovascular infections associated with high-grade bacteremia. Rarely, patients exhibit immunological phenomena associated with chronic bacteremia; complex immune deposition in the kidneys causes dazzling nephritis. More specific information on complications can be found in sections that address specific issues of organ system infection. How should I identify the body? The coNS are grampositive coccis that are divided into clusters "like those of the drug" and are catalysts. The coNS are easily recovered from biological specimens with the use of commercially available automated blood-growing systems or from standard solid media or broth (blood grip, spring-Hinton, brain-heart infusion, triptychal soy, etc.). Due to the amount of necessary biochemical tests, it is difficult to routinely identify all CONS at the species level. However, most of the systems used in modern clinical microbiology laboratories can accurately identify those species most associated with clinical disease, S. epidermidis, S haemolyticus and S sapophyticus. A method to quickly identify S. lugdunensis of other CoNS involves documenting a positive test of L-pyrrolidonyl-beta-naphyhylamide (PYR) and ornithine decarboxylase. Molecular methods have been developed that identify the CNS at the level of species based on the phylogenetic analysis of several preserved DNA sequences. The recovery of biofilms and biomaterial infections coNS has been improved by PCR device sonication and protocols. However, because the CNS is a normal communal body of the skin and mucous membranes, detecting low CNS numbers by polymerase chain reaction (PCR) of surgically removed devices and aspirated from peri-device devices often raises the question of whether the finding is consistent with contamination or true infection. In the recovery situation of CNS from the blood cultures, the doctor often faces determining whether the cultural result represents a true infection or contamination. Factors that can help in this determination include the host situation (is the patient with the highest risk of infection due to the coNS venous catheter [neonate, neutropenic, presence of an intravascular prosthetic device, such as a heart valve, vascular graft or ventral catheter?]); multiple positive blood cultures with the same CoNS strain (same species, same phenotype – antibiogram or biotype) If the blood culture obtained from the periphery becomes positive more than 2 hours more than the blood obtained from the CVC, it is a reasonably sensitive and specific indicator of an infection associated with the CVC CoNS. How does this body cause disease? CoNS can cause diseases due to two characteristics: its natural niche in human skin, giving rise to ready access to medical devices implanted or inserted into the skin, and its ability to adhere to biomaterials and develop biofilm. S. epidermidis has genetic elements such as the Arginine Catabolic Mobile Element (ACME) that are important in its ability to thrive in the relatively dry and acidic conditions that are found in human skin. It produces antibiotics (e.g. epidemin, epilancin, epicidine) that can play a role in bacterial interference and successful persistence in the skin. In contrast to S aureus that produces a large number of adhesins, toxins and factors to prevent host defense, CoNS has relatively few defined virulence factors. The ability of S epidermidis to adhere to biomaterials and form biofilm seems to be the most important feature of virulence. In addition, the ability to secrete poly-gamma-DL glutamic acid (PGA) and phenol soluble modulins (PSM) seem to help in the ability to cause disease. Adherence: The biomaterials placed inside the human host are quickly coated with a "conditioning film" composed of several amphithena serum matrix proteins, such as fibrinogen, fibronectin and elastine. S. epidermidis is able to tie directly to plastics due to the action of autolysins and to interact with the conditioning film due to several adhesives. Biofilm: The growth of CNS in a biofilm is much less susceptible to antibiotics and are more resistant to amphibian defense than the planktonic cells without attack. In addition, it is thought that metabolic quiescent cells found in biofilms allow the tolerance of antibiotics and the persistence of the infection that is the hallmark of an infection based on CoNS biomaterials. Extracellular DNA (eDNA) and polysaccharide intercellular adhesive (PIA) appear to be important functional components of the S. epidermidis biofilm. In addition, alternative protein biofilm components such as the protein associated with accumulation (AAP) and the protein associated with biofilm (Bap) have been described. S epidermidis produces PSMs under the global regulation of the quorum and are important in the ability of organisms to separate from the biofilm and disperse to other sites. Multiple species of CoNS produce PGA that seems to inhibit the host defense and facilitate the colonization of human skin. What is the evidence for specific management and treatment recommendations? Daroucihe, RO. "Treatment of infections associated with surgical implants." N Engl J Med. vol. 350. 2004. pp. 1422-9. (CoNS are a major cause of infection of surgery implants. This review article describes the principles of treatment and the need for surgical intervention.) Fey, PD, Olson, ME. "Concepts present in the formation of biofilm of ". Future Microbiol. vol. 5. 2010. pp. 917-33. (This article analyzes the current knowledge of the adherence of S. epidermidis, formation of biofilm and virulence.) Hall, KK, Lyman, JA. "Updated review of the contamination of the culture of blood." Clin Microbiol Rev. vol. 19. 2006. pp. 788-802. (Approximately 1-5% of blood cultures produce contaminants, and 70-80% of blood culture pollutants are CNS. Hall and Lyman discuss the clinical significance of the contamination of the culture of blood, how to differentiate the contamination of the true infection and how to prevent contamination.) Lewis, K, Spoering, AL, Kaldalu, N, Keren, I, Shah, D, Pace, JL, Rupp, ME, Finch, RG. "Persisteriums: specialized cells responsible for the tolerance of biofilm." Biofilms, infection, and antimicrobial therapy. 2006. pp. 241-56. (This source is a review of biofilm infections, antibiotic tolerance, and persistent cells.)Mermel, LA, Allon, M, Bouza, E. "Clinical practice guidelines for the diagnosis and management of intravascular infection related to the catheter: 2009 updated by the Society of Infectious Diseases of America." Clin Infect Dis. vol. 49. 2009. pp. 1-45. (CNS is the most common cause of nosocomial bacteremia and intravascular catheter infections. In this evidence-based guideline of the Society of Infectious Diseases of America [IDSA], the diagnosis and treatment of infections related to intravascular catheter are examined due to CNS.) Raad, I, Hanna, HA, Alakech, B, Chatzinikolaou, I, Johnson, MM, Tarrand, J. "Diferential time to positivity: a useful methodter for streaming cagesing infection. Ann Intern Med. vol. 140. 2004. pp. 18-25. (The use of the differential-time-position test is tested in this study.) Rogers, KL, Fey, PD, Rupp, ME. "Infections Staphylococcal Coagulase-negative". Infect Dis Clin N Am. vol. 23. 2009. pp. 73-98. (This is an overview of pathogenesis, clinical characteristics and treatment of infections due to CoNS.)Asssor, HS, Jones, RN. "Antimicrobial susceptibility of isolated grampositive bacteria from American medical centers." Diagnos Microbiol Infect Dis. vol. 65. 2009. pp. 158-62. (This is a major surveillance study of 27 American medical centers that test 1153 CoNS strains recovered from patients in 2007 and 2008. This study documents the common multi-resistent phenotype in recovered insulated patients with health-related infections.) Copyright © 2017, 2013 Decision Support in Medicine, LLC. All rights reserved. No sponsor or advertiser has participated, approved or paid for the content provided by the LLC Medical Decision Support. The Licensed Content is copyrighted by DSM. You got an account yet? Log in Copyright © 2021 Haymarket Media, Inc. All rights reserved This material cannot be published, transmitted, rewritten or redistributed in any form without prior authorization. Your use of this website constitutes the acceptance of Haymarket Media and .

Fascinoma Rounds Coagulase negative staphylococcus in the urine - ppt video online download

Coagulase-Negative Staphylococci | Clinical Microbiology Reviews

Study population. CoNS, coagulase-negative staphylococcus; NICU,... | Download Scientific Diagram

Coagulase-Negative Staphylococci | Clinical Microbiology Reviews

Fascinoma Rounds Coagulase negative staphylococcus in the urine - ppt video online download

Staphylococci Coagulase-negative staphylococcus; frequently involved in nosocomial and opportunistic infections S. epidermidis – lives on skin and mucous. - ppt video online download

Results of treatment with cefamandole in 28 infections caused by... | Download Table

The Role of the Coagulase-negative Staphylococci (CoNS) in Infective Endocarditis; A Narrative Review from 2000 to 2020 | Bentham Science

Peritoneal Dialysis–Related Peritonitis due to Coagulase-Negative Staphylococcus: A Review of 115 Cases in a Brazilian Center | American Society of Nephrology

Coagulase-negative staphylococci causing blood stream infection at an Indian tertiary care hospital: Prevalence, antimicrobial resistance and molecular characterisation Singh S, Dhawan B, Kapil A, Kabra S K, Suri A, Sreenivas V, Das

Occurrence of coagulase-negative Staphylococcus in the 188 female... | Download Table

110: Treatment of Coagulase-Negative Staphylococci Infection - Pharmacy Joe -

Fascinoma Rounds Coagulase negative staphylococcus in the urine - ppt video online download

Clinical Case
Comparison of methods for the identification of coagulase-negative staphylococci

Are coagulase-negative staphylococci virulent? - Clinical Microbiology and Infection

Fascinoma Rounds Coagulase negative staphylococcus in the urine - ppt video online download

Staphylococcus in Hospital Practice

Coagulase-Negative Staph Infection: Diagnosis, Symptoms, Treatment

Bacteriology
![PDF] Species identification of coagulase-negative staphylococci from urinary tract isolates. | Semantic Scholar PDF] Species identification of coagulase-negative staphylococci from urinary tract isolates. | Semantic Scholar](https://d3i71xaburhd42.cloudfront.net/ce067965ba06becfbe78ff1a74ad579c97537621/2-Table1-1.png)
PDF] Species identification of coagulase-negative staphylococci from urinary tract isolates. | Semantic Scholar

The Genus staphylococcus.

Are coagulase-negative staphylococci virulent? - ScienceDirect

Coagulase-Negative Staphylococci | Clinical Microbiology Reviews

Coagulase-Negative Staphylococci | Clinical Microbiology Reviews

Staphylococci - Prac. Microbiology
Staph Infection - IM Reference
110: Treatment of Coagulase-Negative Staphylococci Infection - Pharmacy Joe -

Clinical Sources of coagulase-negative staphylococci isolates. | Download Table

Multiplex PCR Based Urinary Tract Infection (UTI) Analysis Compared to Traditional Urine Culture in Identifying Significant Pathogens in Symptomatic Patients - Urology
Significance of Coagulase-Negative Staphylococcus in Urine

Microorganisms | Free Full-Text | Emergence of Staphylococcus lugdunensis as a Cause of Urinary Tract Infection: Results of the Routine Use of MALDI-TOF MS | HTML

Coagulase-Negative Staphylococci | Clinical Microbiology Reviews

Staphylococcus
Coagulase-Negative Staphylococci: Contaminant or Pathogen?

Coagulase-Negative Staphylococci | Clinical Microbiology Reviews

PDF) Coagulase-negative staphylococci: Update on the molecular epidemiology and clinical presentation, with a focus on Staphylococcus epidermidis and Staphylococcus saprophyticus
Asymptomatic bacteriuria among pregnant women referred to outpatient clinics in Sanandaj, Iran
PLOS ONE: Antibiotic Exposure in a Low-Income Country: Screening Urine Samples for Presence of Antibiotics and Antibiotic Resistance in Coagulase Negative Staphylococcal Contaminants

Coagulase Test- Principle, Procedure, Types, Interpretation and Examples
Posting Komentar untuk "coagulase negative staph in urine"